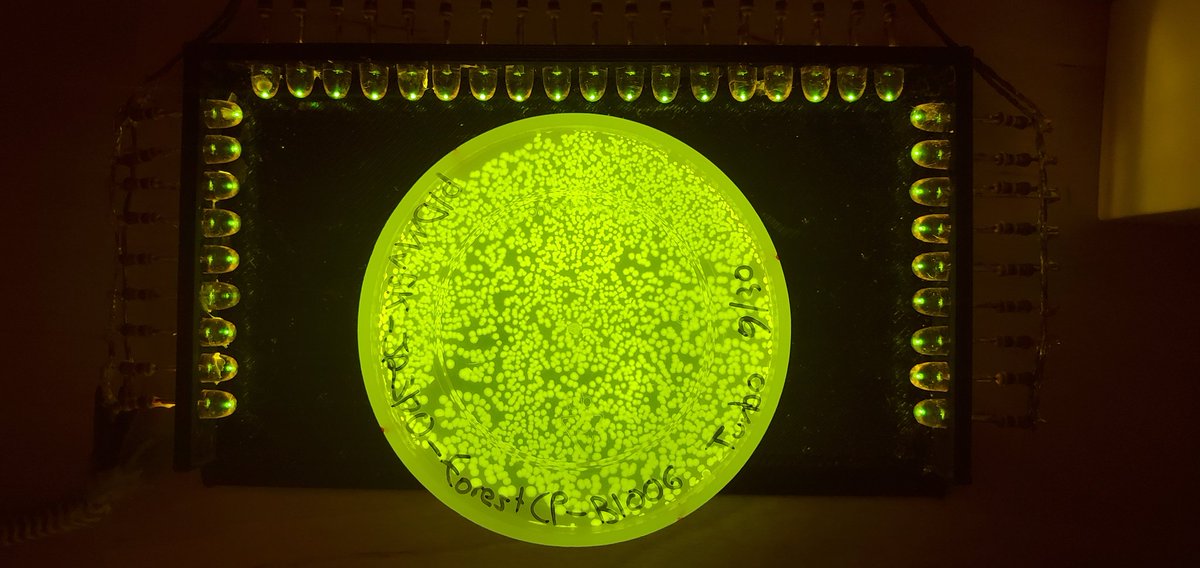
Sebastian S. Cocioba🪄🌷 tweet media

@woodwardsports 1. He wasn't going to signing with us.
2. He's playing on the most successful regular season team of ALL TIME. Of course his point totals were going to go up.
3. He's playing against other team's third lines now instead of first lines.
This isn't rocket science, guys.
English